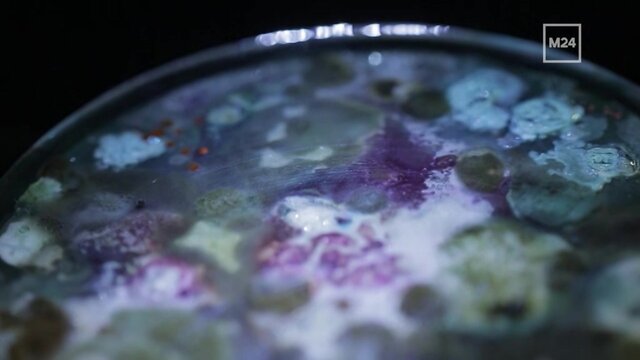

20 минут
"20 минут" – это серия документальных специальных репортажей, в которых журналисты не просто рассказывают о трендах, а показывают, что и кто за ними стоит, чего от них ждать и как можно повлиять. Проведя грамотный фактчекинг, они добиваются тотального погружения, внедряясь в различные процессы: тестируют на себе инновационные разработки, участвуют в социальных экспериментах, меняют профессии, не выдавая себя реального, и даже влияют на ход событий.
В эфире:
Выпуски программы
-
25 октября, 16:00
-
"20 минут": "Матчасть. Пенсии"18 октября, 16:00
-
"20 минут": "Матчасть. Термины"11 октября, 16:00
-
04 октября, 15:50
-
27 сентября, 18:00
-
20 сентября, 18:00
-
16 сентября, 10:45
-
"20 минут": "Матчасть. Мошенники"06 сентября, 12:00
-
"20 минут": замуж за иностранца30 августа, 21:00
-
23 августа, 16:00
-
"20 минут": "Матчасть. Экономика города"16 августа, 16:00
-
09 августа, 16:00
-
02 августа, 16:00
-
26 июля, 20:00
-
20 июля, 02:00
-
12 июля, 20:00
-
05 июля, 20:00
-
28 июня, 20:00
-
"20 минут": мужская депрессия 16+21 июня, 18:00
-
14 июня, 03:00
-
07 июня, 18:00
-
31 мая, 12:00
-
24 мая, 16:00
-
17 мая, 12:00








Собянин рассказал о возможностях для зимнего отдыха в Москве